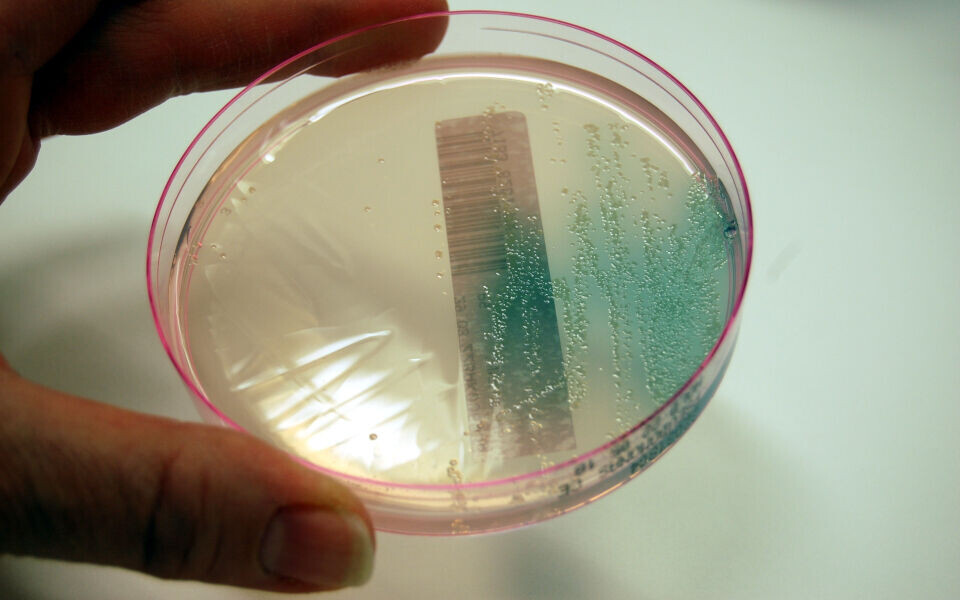

Aktuelt

Jakten på utbruddsbakterien
Kilden til pseudomonasutbruddet som rammet over 300 pasienter på norske sykehus viste seg å være engangsvaskekluter fra Storbritannia. Hvordan etterforskes slike utbrudd? Og hva kan gjøres for å hindre at det skjer igjen?
Tekst og foto: Camilla Sætehaug, frilansjournalist
I november 2021 reagerte en infeksjonsmedisiner ved Universitetssykehuset Nord-Norge i Tromsø på tre dødsfall blant covid-19-pasienter. De tre døde i løpet av kort tid, og dødsårsaken var sepsis med en ny variant av miljøbakterien Pseudomonas aeruginosa. I desember ble utbruddsbakterien påvist hos én pasient på Oslo universitetssykehus og i januar 2022 ble det klart at utbruddet var nasjonalt. Hittil har over halvparten av sykehusene i landet tilfeller av utbruddsbakterien.
- Utbruddsstammen er ikke spesielt resistent, og vil ikke kunne oppdages med vanlig resistenstesting i laboratoriet. Men på grunn av det legen oppfattet som en opphopning av dødsfall, ble isolatene fra de tre første tilfellene helgenomsekvensert og utbruddet ble oppdaget, forteller leder av nasjonal utbruddsgruppe, overlege Kirsten Gravningen ved Folkehelseinstituttet (FHI).

Fra dag én var UNN i kontakt med FHI og de andre helseforetakene i landet. Overlege Heidi Johanne Espvik på Akershus universitetssykehus (Ahus) mener den raske reaksjonen er et sunnhetstegn:
- I mange andre land ville tre dødsfall med pseudomonassepsis ikke vært uvanlig. At man reagerer så raskt i Norge sier mye om hvor lav antibiotikabruk vi har og at vi er våkne.
Tidlig mistanke om felles smittekilde
I romjula 2021 fikk avdeling for smittevern ved Oslo universitetssykehus (OUS) en telefon fra intensivavdelingen på Ullevål. De hadde en opphopning av infeksjoner med Pseudomonas aeruginosa i luftveisprøver. Laboratoriet begynte da å helgenomsekvensere isolatene for å sammenlikne dem med utbruddsstammen fra Tromsø.
- Slik kunne vi se om vår mikrobe var samme sekvenstype som de hadde funnet i Tromsø. Og det var veldig likt! Nesten identisk. Utbruddet hadde spredt seg til OUS, kunne mikrobiolog og molekylærbiolog André Ingebretsen konstatere.
Nettopp fordi isolatene var så like, ble det tidlig spørsmål om det kunne være en felles smittekilde. Samtlige Bioingeniøren har snakket med refererer til at de hadde Dent-O-Sept-saken fra 2002 i bakhodet. Dent-O-Sept var pensler man brukte til munnstell hos sårbare pasientgrupper. Disse penslene var, i likhet med engangsvaskeklutene i denne saken, kontaminert med Pseudomonas aeruginosa.
Mistanken om at det var snakk om et kontaminert produkt ble stadig forsterket. Etterforskerne fant ikke smittekjeder mellom alle pasientene, og bakteriene var så like at de trolig stammet fra samme kilde. I litteraturen dukker P. Aeruginosa ofte opp som kontaminerende agens i medisinske produkter og utstyr. I tillegg hadde Helse Midt-Norge tilfeller som ikke hadde hatt kontakt med OUS eller UNN.
Nitidig arbeid
Ingebretsen ved OUS forteller at en stor del av arbeidet bestod i å risikovurdere utstyr de smittede pasientene var i kontakt med. Sykehusene sendte lange lister over mulige smittekilder til FHI. Videre koordinerte FHI arbeidet og så på om det kunne dreie seg om ett felles produkt som ble brukt på de smittede pasientene.
- Arbeidet var stort og tidkrevende. En av de første listene vi fikk tilbake fra FHI inneholdt flere tusen produkter som var innkjøpt i en definert tidsperiode, forteller Ingebretsen.
Etterforskningen
På sykehus i hele landet arbeidet mikrobiologi- og smittevernavdelingene for å løse mysteriet.
Bioingeniør Bente Borgen ved OUS forteller:
- Det er ikke rutinearbeid å klippe opp en tre meter lang respiratorslange, slik at den kan dyrkes i buljong, inkuberes i varmeskap, og sås ut på skål. Men vi fikk det til!

Mye av laboratoriearbeidet bestod i å finne passende metoder for de ulike utstyrstypene. Alt fra såper og kluter til respiratordeler skulle undersøkes. I begynnelsen var resultatene «ingen vekst» - det var veldig lite Pseudomonas å finne og oppgitthet begynte å prege etterforskerne. Likevel fortsatte de å dyrke ulike produkter. Dersom P. aeruginosa ble påvist skulle den helgenomsekvenseres og sammenliknes med utbruddsstammen før det kunne konkluderes med om det aktuelle tilfellet var en del av utbruddet.
I mars 2022 fikk sykehusene tilgang til en klonspesifikk PCR utviklet av UNN Tromsø. Fra å bruke to-tre dager på sekvensering, tar det nå et par timer å få svar på om bakterien tilhører utbruddet. Det gir raskere svar på om produkter er smittekilde og pasientprøvene avklares raskere. Dermed kan også pasientene isoleres tidligere i forløpet.
En periode mistenkte Ahus at kontamineringen skjedde ved skifte av urinkateter og dyrket derfor urinkatetre i buljong. Mens katetrene lå i buljong, kom beskjeden om at OUS hadde funnet Pseudomonas i vaskeklutene «Oasis Bedbath Unperfumed» fra Vernacare.

Funnet
Espvik på Ahus forteller at man tidlig mistenkte at det måtte dreie seg om et fuktig produkt, siden Pseudomonas trives godt i fuktig miljø. Derfor var disse engangsvaskeklutene, som ofte oppbevares i varmeskap, absolutt en mistenkt smittekilde. Imidlertid dokumenteres vasking av pasienter i liten grad i pasientjournalene, og i tidlige undersøkelser fant verken Ahus eller OUS mikroben i vaskeklutene.
- For Ahus sin del dreide det seg nok om at vi ikke hadde funnet den optimale metoden. Konserveringsmidlene i produktet sørget nok for at det ikke vokste, forklarer Espvik.

Ingebretsen på OUS påpeker at det er vanskelig å finne bakteriene i pakkene med engangskluter, siden distribusjonen av kontaminering i slike pakker er ulik. Én klut i én pakke kan være kontaminert, men ikke resten. Han sier at de ikke-sterile klutene tross alt inneholder mye konserveringsmiddel, og at produsenten skriver tydelig at Pseudomonas er én av bakteriene som ikke skal forekomme.
- Klutene ble anbefalt av smittevern nettopp for at avdelingene ikke skal vaske pasienter med springvann, som kan være kontaminert med Pseudomonas. Men klutene var altså kilden.
Videre arbeid
Når smittekilden nå er funnet, gjenstår mye kartleggingsarbeid for å finne ut av utbruddets utbredelse. Det betyr videre testing av kluter og pasienter.
Kluter fra hvert LOT klippes opp og inkuberes i en Dey-Engley-buljong som hemmer konserveringsmidler. På dag én, to og sju sås buljongen ut på selektiv pseudomonasskål og laktoseskål. Ved vekst identifiseres bakterien ved hjelp av MALDI-TOF massespektrometri og funn av Pseudomonas aeruginosa undersøkes med spesifikk PCR for å påvise utbruddsstammen. Så utføres eventuelt helgenomsekvensering for sammenlikning med utbruddsbakterien.
Per 30. mars hadde Ahus fått vekst fra fire kluter fra to ulike LOT-numre, mens OUS foreløpig hadde funnet utbruddsbakterien i ni kluter.
Bruken av klutene og andre produkter fra samme produsent er stoppet, og pasientene vaskes inntil videre med tørre kluter fuktet med springvann og såpe.
FHI er i dialog med produsenten Vernacare og Mattilsynet, som er tilsynsmyndighet for slike kosmetiske produkter. Produsenten hevder å ha fulgt sine retningslinjer, med stikkprøver i starten, midtveis og til slutt i produksjonsprosessen.
Selv om det er for tidlig å si hva som har skjedd, nevner samtlige av dem Bioingeniøren har vært i kontakt med at Vernacare gjorde endringer i produksjonen i oktober 2021.
- Én teori er at produsenten har introdusert nytt utstyr i produksjonen. Dersom undersøkelsene videre viser at mikroben dukker opp stadig flere steder, ser jeg enda mer alvorlig på dette, sier Ingebretsen.
Lærdom
Ingebretsen mener at arbeidet med dette utbruddet viser at det er viktig å jobbe ut ifra en tanke om «one health», altså at det er en sammenheng mellom mikrober i miljøet, dyr og mennesker. Han påpeker at det er en fordel at sykehus har tilgang til en miljølab, der man kan drive sterilkontroll og undersøke medisinsk utstyr og miljø utenom rutinelaben. Slike laboratorier er en mangelvare i Norge.
- Vi må kunne overvåke miljøet, for det som fins der kan til slutt ende opp i pasienten, konkluderer han.
Overlege Espvik på Ahus mener at en diskusjon som må tas i etterkant av dette, er hvilke krav som skal stilles til produktene man bruker på sårbare pasienter.
- Skal man bytte til en annen type våtserviett? Bruke sterile kluter? Hvor mye vil det koste? Bør man stille andre krav til produsentene? Jeg mener dette er spørsmål man må tenke på fremover.